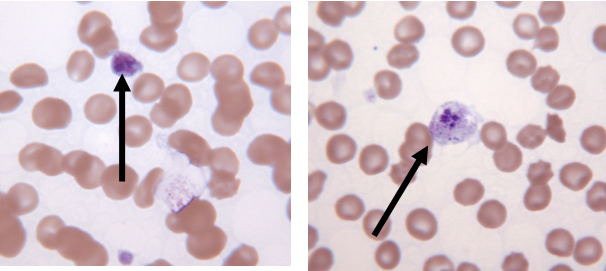

A horse presents to you with a corneal ulcer. You are concerned because it appears to be infected, as shown in this image. You perform cytology and find gram negative rods. What is the most likely organism infecting the corneal ulcer in this horse?
A) E. coli
B) Staphylococcus species
C) Pseudomonas
D) Pasteurella multocida

C) Pseudomonas
Pseudomonas is the most common agent causing bacterial keratitis in the horse. The gram negative cytology provides further evidence that it is the likely culprit. Staphylococcus can cause keratitis in horses but is gram positive. E. coli and Pasteurella are not agents that are commonly involved with keratitis in the horse.
A one-month old foal develops fever, icterus, and diarrhea acutely. Bloodwork shows hyperfibrinogenemia, hypoglycemia, and elevated liver enzymes. Which of these conditions is most likely?
A) Herpesviral hepatitis
B) Clostridium novyi type B
C) Tyzzer’s disease
D) Theiler’s disease
C) Tyzzer’s disease
This is the most likely cause because of the age of the foal and the acute nature of the disease. Tyzzer’s disease is caused by Clostridium piliformis, which causes an acute necrotizing hepatitis. It affects only foals from about 1-6 weeks of age. Theiler’s disease is a condition of adult horses. Clostridium novyi is rare in horses and seen much more in sheep and cattle. Herpesvirus can cause hepatitis but is usually seen at or very soon after birth.
Which infectious agent causes the clinical presentation of pigs most similar to Haemophilus parasuis (Glasser’s disease)?
A) Streptococcus suis
B) Erysipelothrix rhusiopathiae
C) Mycoplasma hyosynoviae
D) Fusobacterium necrophorum
A) Streptococcus suis
Streptococcus suis and H. parasuis both cause polyarthritis, polyserositis, fever, and pneumonia in young piglets up to several weeks of age. Both can cause fibrinopurulent inflammation as well as meningitis and convulsions.
Erysipelas and M. hyosynoviae typically occur in grower and finisher pigs and do not result in pneumonia. Diamond-shaped skin lesions (thus the name “diamond skin disease”) are pathognomonic for Erysipelas. Fusobacterium necrophorum causes lameness via footrot or laminitis.
You are asked to examine some feeder pigs that have stopped eating yesterday. The group is lying down and seems lethargic. They have fevers of 105-106F (40.6 -41.1 C), firm dry feces, and the skin has rhomboid-shaped red blotches scattered on it. Why is the likely pathogen and what treatment should be recommended?
A) Metronidazole
B) Chloramphenicol
C) Gentamicin
D) Penicillin
E) Streptomycin
Erisipelothrix rhusiopathiae; D) Penicillin
Erysipelas is susceptible to penicillins, as well as tetracyclines (usually), lincomycin and tylosin. Chloramphenicol and nitroimidazoles (including metronidazole) are not approved for food animal use.
A 3-year old female spayed indoor/outdoor domestic short hair presents for congestion and swelling over the bridge of the nose. The swelling over the nose is firm and seems to be subcutaneous. There is also mild enlargement of the mandibular lymph nodes. You perform cytology from a fine needle aspirate of the swelling over the nose and see narrow, budding, thin-walled yeasts surrounded by clear capsules (see picture). You also detected a lesion in the retina on fundic examination. What is the most likely organism and which of the following treatments would be indicated?

A) Trimethoprim sulfa
B) Amoxicillin-clavulanic acid
C) Itraconazole
D) Lufenuron
E) Doxycycline
Cryptococcus neoformans; C) Itraconazole
This is a fungal disease that occurs when the organism is inhaled and is disseminated to skin, eyes, CNS, lungs, or other areas. The upper respiratory tract is most often involved and symptoms can include nasal discharge, sneezing, swelling over the nose, and regional lymphadenopathy. If the CNS is involved, seizures can also occur. The disease has been thought to be transmitted most often through infected pigeon droppings. Itraconazole or fluconazole are the anti-fungals of choice for this disease. Doxycycline, Trimethoprim sulfa, and Clavamox are all antibiotics and would not address a fungal infection. Lufenuron is a flea treatment that has had some implications for treatment of dermatophytes due to its ability to inhibit chitin. About 1/3 of the cell wall of a fungus is composed of chitin. This has not been a promising or approved treatment for ringworm and surely would not be an appropriate treatment for Cryptococcus.
A 2-year old nonlactating dairy cow in California has a sudden onset of head tilt and drooling. The owner also reports that she appears less active and less interested in feed than normal, and today is circling in one direction in the pen. You examine her and find T=105F, HR=96, and RR=32. There is ptosis, drooped ear, and weakness of the lips on the affected side. You take a lumbosacral spinal tap (see photo), and submit the CSF to your lab. The results show elevated protein and WBCs, with the cell type being mainly monocytes. The lab reports seeing some gram positive bacteria in the monocytes of the CSF. Based on these findings what is the most likely organism and best treatment for this condition?

A) Metoclopramide
B) Enrofloxacin
C) Metronidazole
D) Penicillin
E) Chloramphenicol
Listeria monocytogenes; D) Penicillin
Listeria monocytogenes can effectively be treated in the early stages of the disease with penicillin, ampicillin, or tetracycline. Intramuscular procaine penicillin for example has a withdrawal of 10 days for slaughter (meat) and 48 hours for milk if the animal is lactating. Other choices of approved antimicrobials would also likely be effective since L. monocytogenes is susceptible to most antimicrobials. For a list of approved animal drugs see www.farad.org/vetgram. FARAD is the United States Food Animal Residue Avoidance Databank which gives withdrawal information as well as a list of prohibited drugs. The other drugs listed as choices here are prohibited and cannot be legally used in food animals in the USA.
The image shows an infarct in the liver discovered on post mortem exam of a mature beef cow which died one hour before in a western mountain pasture, after being observed to appear normal one day earlier. There is also dark red urine in the bladder. The pasture contains native plants, some pine trees, and a marshy area with water plants. The cows are unvaccinated and were never wormed.
Given this history and the lesion found, the most likely cause of death is _________.

A) Viral hepatitis
B) Pine needle poisoning
C) Death camas toxicity
D) Blue-green algae toxicity
E) Bacillary hemoglobinuria
Clostridium novyi; E) Bacillary hemoglobinuria
Also known as redwater, bacillary hemoglobinuria is caused by germination of Clostridium Novyi type D spores in the liver after anaerobic damage by migrating liver fluke larvae. Cl. Novyi was formerly called Cl. hemolyticum. Vaccination can prevent this disease.
Several litters of 2 to 3 day old pigs have recently died rapidly with hemorrhagic enteritis. Post mortem lesions include mucosal hemorrhage, necrosis and emphysema in the small intestines. What pathogen is most likely to cause these signs?
A) Haemophilus parasuis
B) Enterotoxigenic E. coli
C) Erysipelothrix rhusiopathiae
D) Clostridium perfringens type C
E) Salmonella choleraesuis
D) Clostridium perfringens type C
The combination of Malassezia, Pseudomonas, and Staphylococcus pseudintermedius is commonly present in cases of:
A) Johne’s chronic wasting disease in cattle
B) proliferative enteritis in swine
C) late-term abortion in ewes
D) pneumonia in adult horses
E) chronic ear infection in dogs
E) Chronic ear infection
Of the following, this caseous lymphadenitis is likely caused by:
A) Bacillus anthracis
B) Lawsonia intracellularis
C) Histophilus somni
D) Listeria monocytogenes
E) Corynebacterium pseudotuberculosis

E) Corynebacterium pseudotuberculosis
In pigs, a common manifestation of Yersinia enterocolitica infection is:
A) conjunctivitis
B) pneumonia
C) arthritis
D) orchitis
E) dysentery
E) dysentery
The appearance of these thrombocytes from a dog with fever, malaise, and anorexia is most suggestive of infection with:
A) Mycoplasma haemocanis
B) Salmonella enterica
C) Ehrlichia ewingii
D) Borrelia burgdorferi
E) Anaplasma platys
E) Anaplasma platys
Face flies may transmit this microorganism to cause “pinkeye” conjunctivitis in cattle:
A) Francisella tularensis
B) Corynebacterium renale
C) Shigella sonnei
D) Dermatophilus congolensis
E) Moraxella bovis
E) Moraxella bovis
A final diagnosis of tetanus is most consistent with which of the following case presentations:
A) 8-yr-old Cocker Spaniel referred because of chronic inflammatory ear disease; history of episodic pruritis and pyoderma over the past 4 years
B) mature ram with a swollen testis; upon examination after surgical removal, the testis contained multifocal pyogranulomas with caseous abscesses of the epididymis
C) 10-wk-old moribund kitten euthanized at owner’s request; the lungs were consolidated and mottled dark red-gray, with marked alveolar infiltrates of neutrophils and macrophages
D) 2-day-old colt with mild colic and bloody diarrhea 12 - 24 hr after birth
E) 6-mo-old recently spayed German Shepherd with moderate respiratory distress, extensor muscle rigidity, and contracted pupils
E) 6-mo-old recently spayed German Shepherd with moderate respiratory distress, extensor muscle rigidity, and contracted pupils
This dimorphic agent of systemic mycosis produces infectious arthroconidia in the hot dry soils of the desert southwest United States:
A) Coccidioides immitis
B) Blastomyces dermatitidis
C) Sporothrix schenckii
D) Histoplasma capsulatum
E) Cryptococcus neoformans

A) Coccidioides immitis
This bacteria is transmitted by the bite of a soft tick (Argus persicus) to cause splenomegaly in birds:
A) Salmonella enterica
B) Chlamydophila psittaci
C) Francisella tularensis
D) Borrelia anseris
E) Leptospira bratislava
D) Borrelia anseris
The Sterne vaccine, consisting of live attenuated Bacillus bacteria, is administered to cattle to control:
A) footrot
B) shipping fever
C) anthrax
D) Johne’s disease
E) thromboembolic meningoencephalitis
C) Anthrax
The American Association of Feline Practitioners recommends annual intranasal vaccination with an attenuated strain of this bacteria for cats with sustained risk seen in general practice, as well as for shelter cats:
A) Bordetella bronchiseptica
B) Clostridium tetani
C) Clostridium botulinum
D) Leptospira grippotyphosa
E) Borrelia burgdorferi
A) Bordetella bronchiseptica
Potential gram-positive organisms
Staphylococcus, Streptococcus, Enterococcus, Arcanobacterium, Trueperella, Bacillus, Corynebacterium, Erysipelothrix, Listeria, Rhodococcus, Clostridium, Actinomyces, Dermatophilus
Gram Positive organisms with vaccinations and species they are used in:
Streptococcus equi equi- Equine “Strangles”
Bacillus anthracis- Cattle “Anthrax”
Erysipelothrix rhusiopathiae- Swine (4 way) “Diamond skin disease”
Clostridium: Histotoxic- Cattle “Blackleg”, “Tyzzer’s”, “Red Water”; Neurotoxic- Tetanus/Botulism
Gram Negative organisms with vaccinations and the species used in:
Escherichia coli- Cattle, Swine “EPEC”, “EHEC”
Pasteurella multocida- Swine (4 way), calves/feedlot cattle
Mannheimia haemolytica- Cattle “shipping fever”
Actinobacillus suis- Swine (4 way) pig pneumonia
Haemophilus paragallinarum- birds (Bird coryza)
Histophilus somni- Cattle “TEME”
Bordetella bronchiseptica- Dog/Cats/Swine (4 way) “Kennel Cough”, Atrophic rhinitis with P. multocida (Swine)
Moraxella spps- Cattle (7- way clostridial) “Pink Eye”
Brucella abortus - Cattle (RB51) “Bang’s” abortion
Lawsonia intracellularis- Swine “Wet tail”
Borrelia burgdorferi- Dogs “Lyme disease”
Leptospira- Dogs, Cattle, Swine “Moon Blindness”
Other organisms with vaccinations and the species they are used in:
Mycoplasma bovis/mycoides- CBPP/CCPP
Chlamydophila- Cats/Swine/Ruminants EAE, conjunctivitis, psittacosis, sporadic bovine encephalomyelitis
A 6-year old Friesian cow presents to you with a mass on the left mandible (see image). The farmer reports that the mass has developed over the last several weeks and the cow has recently had some difficulty eating and lost weight. On examination, the mass is firm, immobile, and painful on manipulation. You note a thick discharge with small granular particles. Based on the most likely diagnosis, What is the most likely causative agent and what should you tell the farmer?
A) Treatment with sodium iodide intravenously is likely curative but the cow’s milk and meat will not be suitable for human consumption for 120 days
B) The most effective treatment is oral sodium iodide
C) Intravenous penicillins are likely to be effective
D) Treatment is unlikely to be successful and the cow should be culled
Actinomyces bovis (“lumpy jaw”)/ D) Treatment is unlikely to be successful and the cow should be culled
The keys to the diagnosis are the firm mass that is immobile over the mandible. The presence of “sulfur granules” in the discharge is also a characteristic finding with this disease. Unfortunately, simply making the diagnosis is not sufficient to answer this question correctly. All of the answer choices are potential treatments for lumpy jaw but this represents a moderate to severe case which is unlikely to respond to treatment due to difficulty in achieving the necessary antibiotic concentration over a sustained period. Therefore, the best answer choice in this case is to cull the cow.
(unlikely to be asked this was as an exam question)
What agent contributes to sheep head tilt?
Listeria









